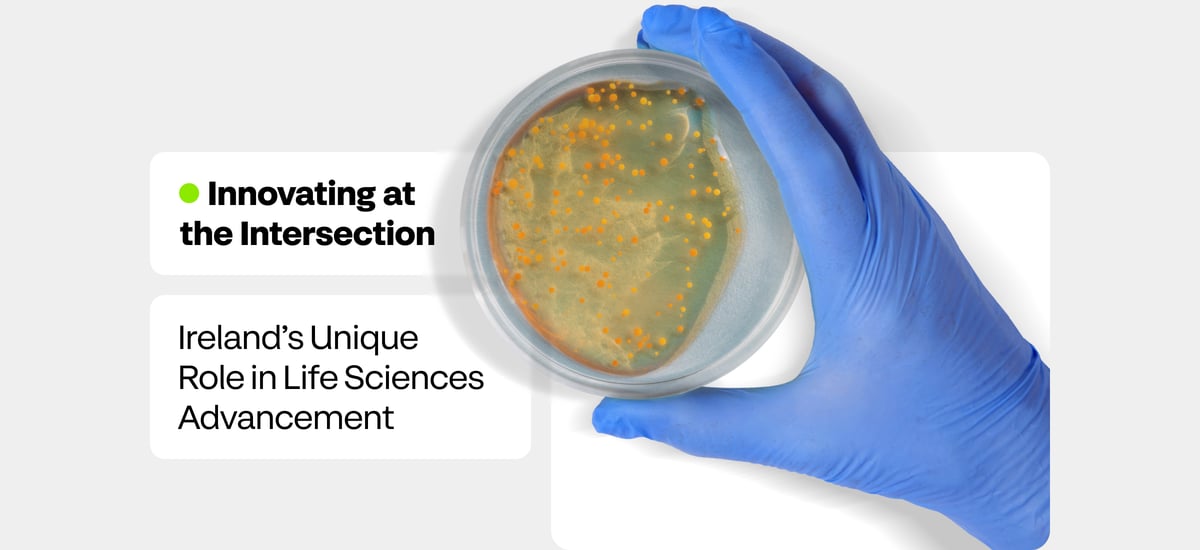
Innovating at the Intersection

Innovating at the Intersection
In the battle to detect cancer, fluorescent dye and an infrared camera have long been part of the clinician’s armory.
Injecting dye can help identify telltale differences in blood flow linked to cancerous tissue. However, even experienced surgeons find it highly challenging to interpret the images produced.
Now, scientists in Ireland are using the latest digital advances to boost oncology diagnostics, harnessing biophysics-inspired AI tools to reveal subtle changes in tissue and blood flow that are undetectable even by a skilled human eye.
To bring this innovation to life, IBM Research Ireland has teamed up with Deciphex, a pathology-focused AI enterprise, to launch a partnership with medics at Mater Misericordiae University Hospital–University College Dublin and biochemists from the Royal College of Surgeons in Ireland (RCSI).
This collaboration is giving clinicians critical new information as they perform surgery, through an augmented reality (AR) view overlaid on their real-time imaging feed.
Elsewhere in Ireland, HAON Life Sciences is leading a partnership to deliver a pioneering cell therapy to treat brain injuries in newborn babies. The target is hypoxic ischemic encephalopathy (HIE), a leading cause of infant mortality and long-term neurological disability.
This project also draws on multiple disciplines: Clinical expertise comes from University College Cork’s INFANT Research Centre, and analytical input from the National Institute for Bioprocessing Research and Training. Galway-based HiTech Health will bring its advanced manufacturing expertise to deliver the finished drug.
These are just two of the growing number of Irish partnerships where life sciences intersect with other era-defining trends—such as smart medical technologies, digital health and advanced manufacturing—to deliver practical medical breakthroughs that benefit patients.
Driven by aging populations and a demand for personalized care, investments in healthtech are expected to see a CAGR of nearly 16% in the seven years to 2027. Artificial intelligence will be a critical lever: The European medical technology trade association, MedTech Europe, has estimated that AI could save 400,000 lives every year.
Ireland, in particular, is poised to capitalize on these opportunities. Its specialized research centers, from CÚRAM in Galway to Tyndall Institute in Cork, are catalyzing innovations across traditional boundaries. These advancements are underpinned by state funders such as the Disruptive Technologies Innovation Fund, which recently awarded €5.7 million to an oncology project led by RCSI and Mater Misericordiae University Hospital in partnership with Deciphex and IBM Research, and €10.7 million to HAON’s neonatal cell therapy effort.
Brendan O’Callaghan, Executive Vice President, Manufacturing and Supply at multinational biopharma company Sanofi, sees huge potential in Ireland’s medical technology and health care ecosystem.
“When you put such a concentration of different sectors together across tech, medtech and biopharma, within the proximity and intimacy that a country of Ireland’s size offers, with its strong social networks, you get a lot of connections,” he observes. “It’s like free electrons that are colliding, generating positive energy in the form of inspiration and innovation.”
The sector’s growth in Ireland also depends on other factors. O’Callaghan points to the need for substantial further investment in the energy infrastructure required to both power the data revolution and to resolve the housing crisis that has threatened growth.
Nevertheless, the country is already burnishing its status as a tech beacon. Sanofi’s Waterford site is one of a handful of the company’s 39 global sites selected as a “digital lighthouse” to pilot and prove AI-powered capabilities prior to rolling out these innovations across its global network.
With a wealth of talent wielding tech, science and engineering degrees, Ireland boasts the highest concentration per capita of STEM graduates in their 20s. With their ability to work across disciplines, this cadre is speeding the lab-to-market transition.
John Nugent, Head of Medical Technologies and Healthcare Services at IDA Ireland, has seen many of these graduates focus on perfecting late-stage commercial processes in their research work, supported by the National Institute for Bioprocessing Research & Training (NIBRT) and Digital Manufacturing Ireland (DMI), before moving into earlier-stage research.
“That is really helping accelerate the journey, because they started in late-stage commercial research and they’re working their way back into more fundamental research,” says Nugent. “It’s reverse engineering the research landscape.”
This approach is also reflected at the company level: Medtechs with a track record of producing products are finding that their experience eases early-stage processes as they apply cutting-edge techniques to new developments in their pipelines.
Commercialization opportunities are boosted by the ADI Catalyst innovation and collaboration hub launched in Limerick in 2022 by Analog Devices. Health care is one of the themes of the center, which provides a space for SMEs and partners to collaborate, and connects health-focused entrepreneurs with digital expertise.
Ireland’s opportunities aren’t confined to health care businesses, and Irish tech companies outside the specialized sector are also finding health-related applications for their innovations, often through links made by the plethora of research centers.
“They’re giving those companies the opportunity to partner together on research projects that are directly applicable to health,” says Nugent, “whether that’s wearables for patient monitoring, medication management, high-security networks within hospital settings for the transmission of data, and robotic surgery.” As Ireland continues to foster productive connections between pharma, tech and medical innovation, more breakthroughs will likely emerge from these creative collaborations.